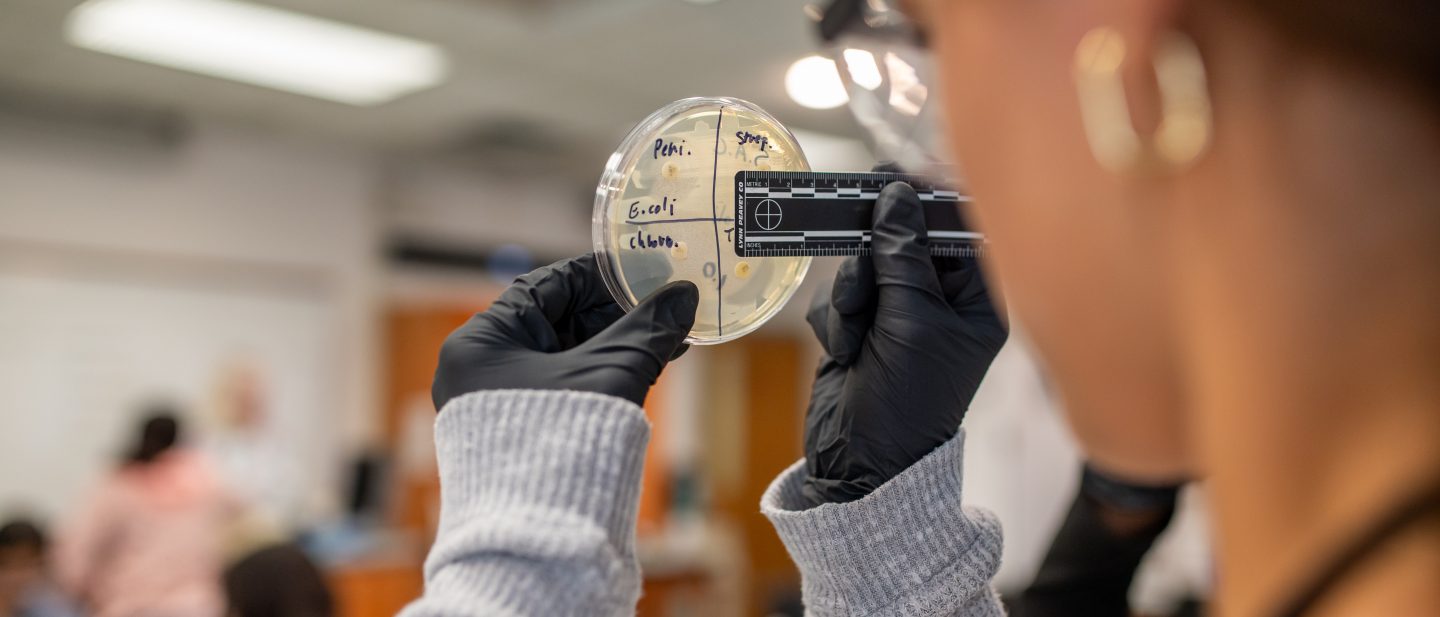

Pre-Med: Microbiology, Nutrition and Human Disease
About the Course
Step into the world of modern biology and medicine through this immersive summer course. You’ll explore how evolution, genetics, and cell biology shape human health—and how science drives innovation in the prevention and treatment of disease.
Through engaging lectures and interactive lab activities, you’ll examine real-world issues in healthcare from an interdisciplinary perspective, connecting scientific discovery to its impact on individuals and society.
Students with interests in biology, medicine, or healthcare will gain a strong foundation for future college study and careers in the health professions.
Course Details
- Credits: 3
- Location: Adelphi University, Garden City, NY campus
- Dates: July 12–August 1, 2026
- Schedule: Monday–Thursday, 10:00am–2:30pm

Adelphi biology professor Jonna M. Coombs works with pre-college students during a hands-on class at Adelphi’s Garden City, NY campus.
What You’ll Learn
By the end of the course, you will:
- Enroll in a Biology course taught by an Adelphi University professor
- Earn certification in CPR in a course approved by the American Heart Association.
- Become “Stop the Bleed” certified
- Discover pathways for continued study in Adelphi’s Pre-Professional and Joint Degree programs in healthcare and pre-med.
Meet Your Professor
Jonna Coombs, PhD is a Microbial Ecologist, which is a fancy way of saying that she studies microscopic organisms and their relationship with the world around them.
This includes the interaction of microbes with other organisms like human beings. Her research focus is bioremediation, which is the use of living organisms to “clean up” pollutants in the environment. Specifically, she looks at heavy metals such as zinc, cadmium and lead. Because heavy metals are elements on the periodic table, they cannot be broken down, but instead can be changed into less-toxic forms or locked into molecules that are not soluble in water. This can help to decontaminate polluted environments. Dr. Coombs had a B.S. in Biology from the University of Maine, and a Ph.D. from Penn State University. She joined the faculty at Adelphi University in 2005.